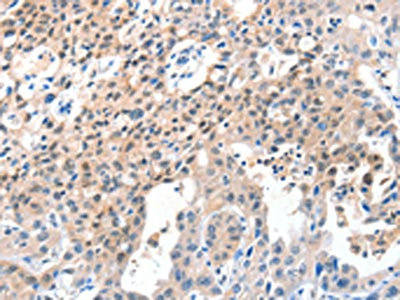

CASP7 Antibody
-
中文名稱:CASP7兔多克隆抗體
-
貨號:CSB-PA759135
-
規格:¥1100
-
圖片:
-
The image on the left is immunohistochemistry of paraffin-embedded Human thyroid cancer tissue using CSB-PA759135(CASP7 Antibody) at dilution 1/25, on the right is treated with fusion protein. (Original magnification: ×200)
-
The image on the left is immunohistochemistry of paraffin-embedded Human lung cancer tissue using CSB-PA759135(CASP7 Antibody) at dilution 1/25, on the right is treated with fusion protein. (Original magnification: ×200)
-
-
其他:
產品詳情
-
Uniprot No.:
-
基因名:
-
別名:apoptosis-related cysteine peptidase antibody; Apoptotic protease Mch-3 antibody; CASP-7 antibody; CASP7 antibody; CASP7_HUMAN antibody; Caspase-7 subunit p11 antibody; CMH-1 antibody; ICE-LAP3 antibody; ICE-like apoptotic protease 3 antibody
-
宿主:Rabbit
-
反應種屬:Human,Mouse
-
免疫原:Fusion protein of Human CASP7
-
免疫原種屬:Homo sapiens (Human)
-
標記方式:Non-conjugated
-
抗體亞型:IgG
-
純化方式:Antigen affinity purification
-
濃度:It differs from different batches. Please contact us to confirm it.
-
保存緩沖液:-20°C, pH7.4 PBS, 0.05% NaN3, 40% Glycerol
-
產品提供形式:Liquid
-
應用范圍:ELISA,IHC
-
推薦稀釋比:
Application Recommended Dilution ELISA 1:2000-1:5000 IHC 1:25-1:100 -
Protocols:
-
儲存條件:Upon receipt, store at -20°C or -80°C. Avoid repeated freeze.
-
貨期:Basically, we can dispatch the products out in 1-3 working days after receiving your orders. Delivery time maybe differs from different purchasing way or location, please kindly consult your local distributors for specific delivery time.
-
用途:For Research Use Only. Not for use in diagnostic or therapeutic procedures.
相關產品
靶點詳情
-
功能:Involved in the activation cascade of caspases responsible for apoptosis execution. Cleaves and activates sterol regulatory element binding proteins (SREBPs). Proteolytically cleaves poly(ADP-ribose) polymerase (PARP) at a '216-Asp-|-Gly-217' bond. Overexpression promotes programmed cell death. Cleaves phospholipid scramblase proteins XKR4, XKR8 and XKR9.; Lacks enzymatic activity.
-
基因功能參考文獻:
- Pyrin signaling is dispensable for Clostridium difficile infection (CDI) associated intestinal epithelial cells death and for in vivo pathogenesis; C. difficile enterotoxins induce activation of executioner caspases 3/7 via the intrinsic apoptosis pathway indicating that caspase-3/7-mediated intestinal epithelial cells apoptosis is critical for in vivo host defense during early stages of CDI. PMID: 30451870
- CASP8: rs1045494 (C > T), PIK3R1: rs3756668 (A > G) and CASP7: rs4353229 (T > C), were associated with longer overall survival in limited disease-small cell lung cancer patients after chemoradiotherapy PMID: 26988918
- Results show that caspase-7 is phosphorylated by PAK2 at S239 which inhibits its activity by two divergent mechanisms prior to and following caspase activation: initial phosphorylation allosterically slows activation by upstream initiator caspases by impeding cleavage at the intersubunit linker and a second phosphorylation site directly blocks substrate binding. PMID: 27889207
- Caspase-7 regions involved in the interaction with Hsp90 co-chaperone p23 and substrate recognition. PMID: 28863261
- Study provides evidence that a loss-of-function variant rs10553596 in CASP7 associates with significantly reduced Alzheimer's disease incidence in elder populations. PMID: 27358062
- Low expression of CASP7 is associated with non-small cell lung cancer. PMID: 26307684
- Compared with the TT genotype, the rs10787498GT genotype was associated with an increased cervical cancer risk. PMID: 25784056
- Phosphorylate caspase-7 bu Src at multiple tyrosine sites enhanced its cellular apoptotic effect. PMID: 24407236
- Potentially functional polymorphisms in the CASP7 gene contribute to gastric adenocarcinoma susceptibility in an eastern Chinese population. PMID: 24040159
- showed that CASP7 is downregulated in primary prostate tumors and metastatic lesions across multiple data sets PMID: 22986525
- Genetic variations of CASP7 may modulate overall survival and progress-free survival of patients with advanced non-small cell lung cancer treated with platinum-based chemotherapy. PMID: 22441531
- genetic polynorphism is associated with the risk of childhood leukemia PMID: 22548721
- XIAP does not function as a NEDD8-E3 ligase for caspase-7 in vivo PMID: 22584050
- Cellular expression of caspase-7 lacking the critical lysine residues resulted in less-efficient PARP and p23 cleavage compared with cells expressing the wild-type peptidase. PMID: 22451931
- identify serine 118 in the transactivation domain of YY1 as the site of CK2alpha phosphorylation, proximal to a caspase 7 cleavage site PMID: 22184066
- Caspase-7 cleaves human TERT at residues E286 and D628 as part of the apoptosis pathway in cultured cells. PMID: 21936563
- highly expressed PAK2 mediates chemotherapeutic resistance in human breast invasive ductal carcinoma by negatively regulating caspase-7 activity PMID: 21555521
- The RIPK1 and CASP7 polymorphisms can be considered as possible prognostic markers for survival after curative resection in patients with colorectal cancer. PMID: 20567846
- Caspase-8 and caspase-7 sequentially mediate proteolytic activation of acid sphingomyelinase in TNF-R1 receptosomes. PMID: 21157428
- Single Nucleotide Polymorphisms in CASP7 is asspciated with lung cancer. PMID: 20661084
- caspase 7 cleavage of ORF57 may represent a cellular function against lytic KSHV infection PMID: 20159985
- Specifically interfering with caspase-7 activation may hold therapeutic value for the treatment of cancer and inflammatory ailments. PMID: 19782763
- Pro-CASP7 was detected in mitochondria, cytosol, nucleus, and microsomes of U937 cells. During TPA-induced differentiation, it moved to the mitochondria. PMID: 12145703
- caspase 9 by itself can activate caspase 7 in the absence of the caspase 3-dependent pathway in TNF-alpha-induced apoptosis PMID: 12804035
- the N-peptide of caspase 7 serves to physically sequester the caspase-7 zymogen in a cytosolic location that prevents access by upstream activators PMID: 12824163
- our data suggest that the inactivating mutations of the CASPASE-7 gene might lead to the loss of its apoptotic function and contribute to the pathogenesis of some human solid cancers PMID: 12970753
- caspase-7 is involved earlier than other effector caspases in apoptosis PMID: 14583630
- cleavage of Claspin by caspase-7 inactivates the Chk1 signaling pathway PMID: 16123041
- Caspase 7 activation is a prominent feature in periodontitis-associated tissue injury. PMID: 16213496
- Promoters of CASP7 genes are modulated by prohibitin. PMID: 16918502
- AIF overexpression specifically resulted in the activation of caspase-7, thereby amplifying the inhibition of protein synthesis including eIF3g cleavage. PMID: 17094969
- observation indicates that neither CASP7 nor CASP8 mutation may occur in gastrointestinal lymphomas, and suggests that neither of them may play an important role in the development of gastrointestinal lymphomas PMID: 17532763
- crystal structures show that the S2 pocket of caspase-7 can accommodate diverse residues PMID: 17697120
- A reticulon protein is identified as one out of a selected number of caspase targets during apoptosis and as a novel substrate for Cdk1 and 2.[ PMID: 18072206
- These results revealed that caspase-7 has a novel role during cell cycle progression at mitosis. PMID: 18459962
- Valosin-containing protein was cleaved by both capspase-7 and caspase-3 in vitro and during apoptosis; degradomic approach to caspase-7 provides new candidate substrates and valuable clues to the specific function of caspase-7 in apoptosis PMID: 18596415
- CASP7 (caspase 7) rs2227309 SNP was not associated with rheuatoid arthritis (RA) in a European Caucasian population. CASP7 isoforms alpha and beta could have an involvement in the apoptosis process in RA PMID: 18785314
- Modulation of effector caspase-7 cleavage determines response of breast and lung tumor cell lines to chemotherapy. PMID: 19241192
- Results show that caspase 7, as an SREBP-1/2 target, can be induced under mevalonate-restricting conditions, which might help overcome its shortage. PMID: 19323650
- These findings suggest that genetic variants in caspase-3 and caspase-7 may play a role in endometrial cancer susceptibility. PMID: 19531679
- Dissecting an allosteric switch in caspase-7 using chemical and mutational probes. PMID: 19581639
- there is an an association between HCV core and HAX-1, which promotes 5-FU mediated p53-dependent caspase-7 activation and hepatocyte growth inhibition PMID: 19605487
顯示更多
收起更多
-
亞細胞定位:Cytoplasm.
-
蛋白家族:Peptidase C14A family
-
組織特異性:Highly expressed in lung, skeletal muscle, liver, kidney, spleen and heart, and moderately in testis. No expression in the brain.
-
數據庫鏈接:
Most popular with customers
-
YWHAB Recombinant Monoclonal Antibody
Applications: ELISA, WB, IHC, IF, FC
Species Reactivity: Human, Mouse, Rat
-
Phospho-YAP1 (S127) Recombinant Monoclonal Antibody
Applications: ELISA, WB, IHC
Species Reactivity: Human
-
-
-
-
-
-
VDAC1 Recombinant Monoclonal Antibody
Applications: ELISA, WB, IHC
Species Reactivity: Human, Mouse, Rat